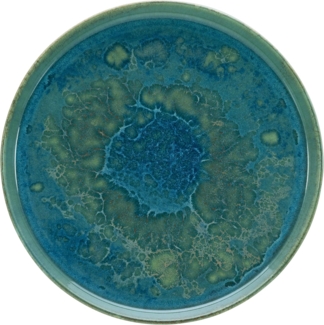
CreaTable, 21508, Serie Yuki, Speiseteller 4 teilig

Diese Cookies und andere Informationen sind für die Funktion unserer Services unbedingt erforderlich. Sie garantieren, dass unser Service sicher und so wie von Ihnen gewünscht funktioniert. Daher kann man sie nicht deaktivieren.
Zur Cookierichtlinie

-52%
12Punkte
Weitere Varianten
+6
CreaTable 22050 Nature Collection Speiseteller 27 cm, grün (6er Pack)
485
47,18 €UVP99,99 €